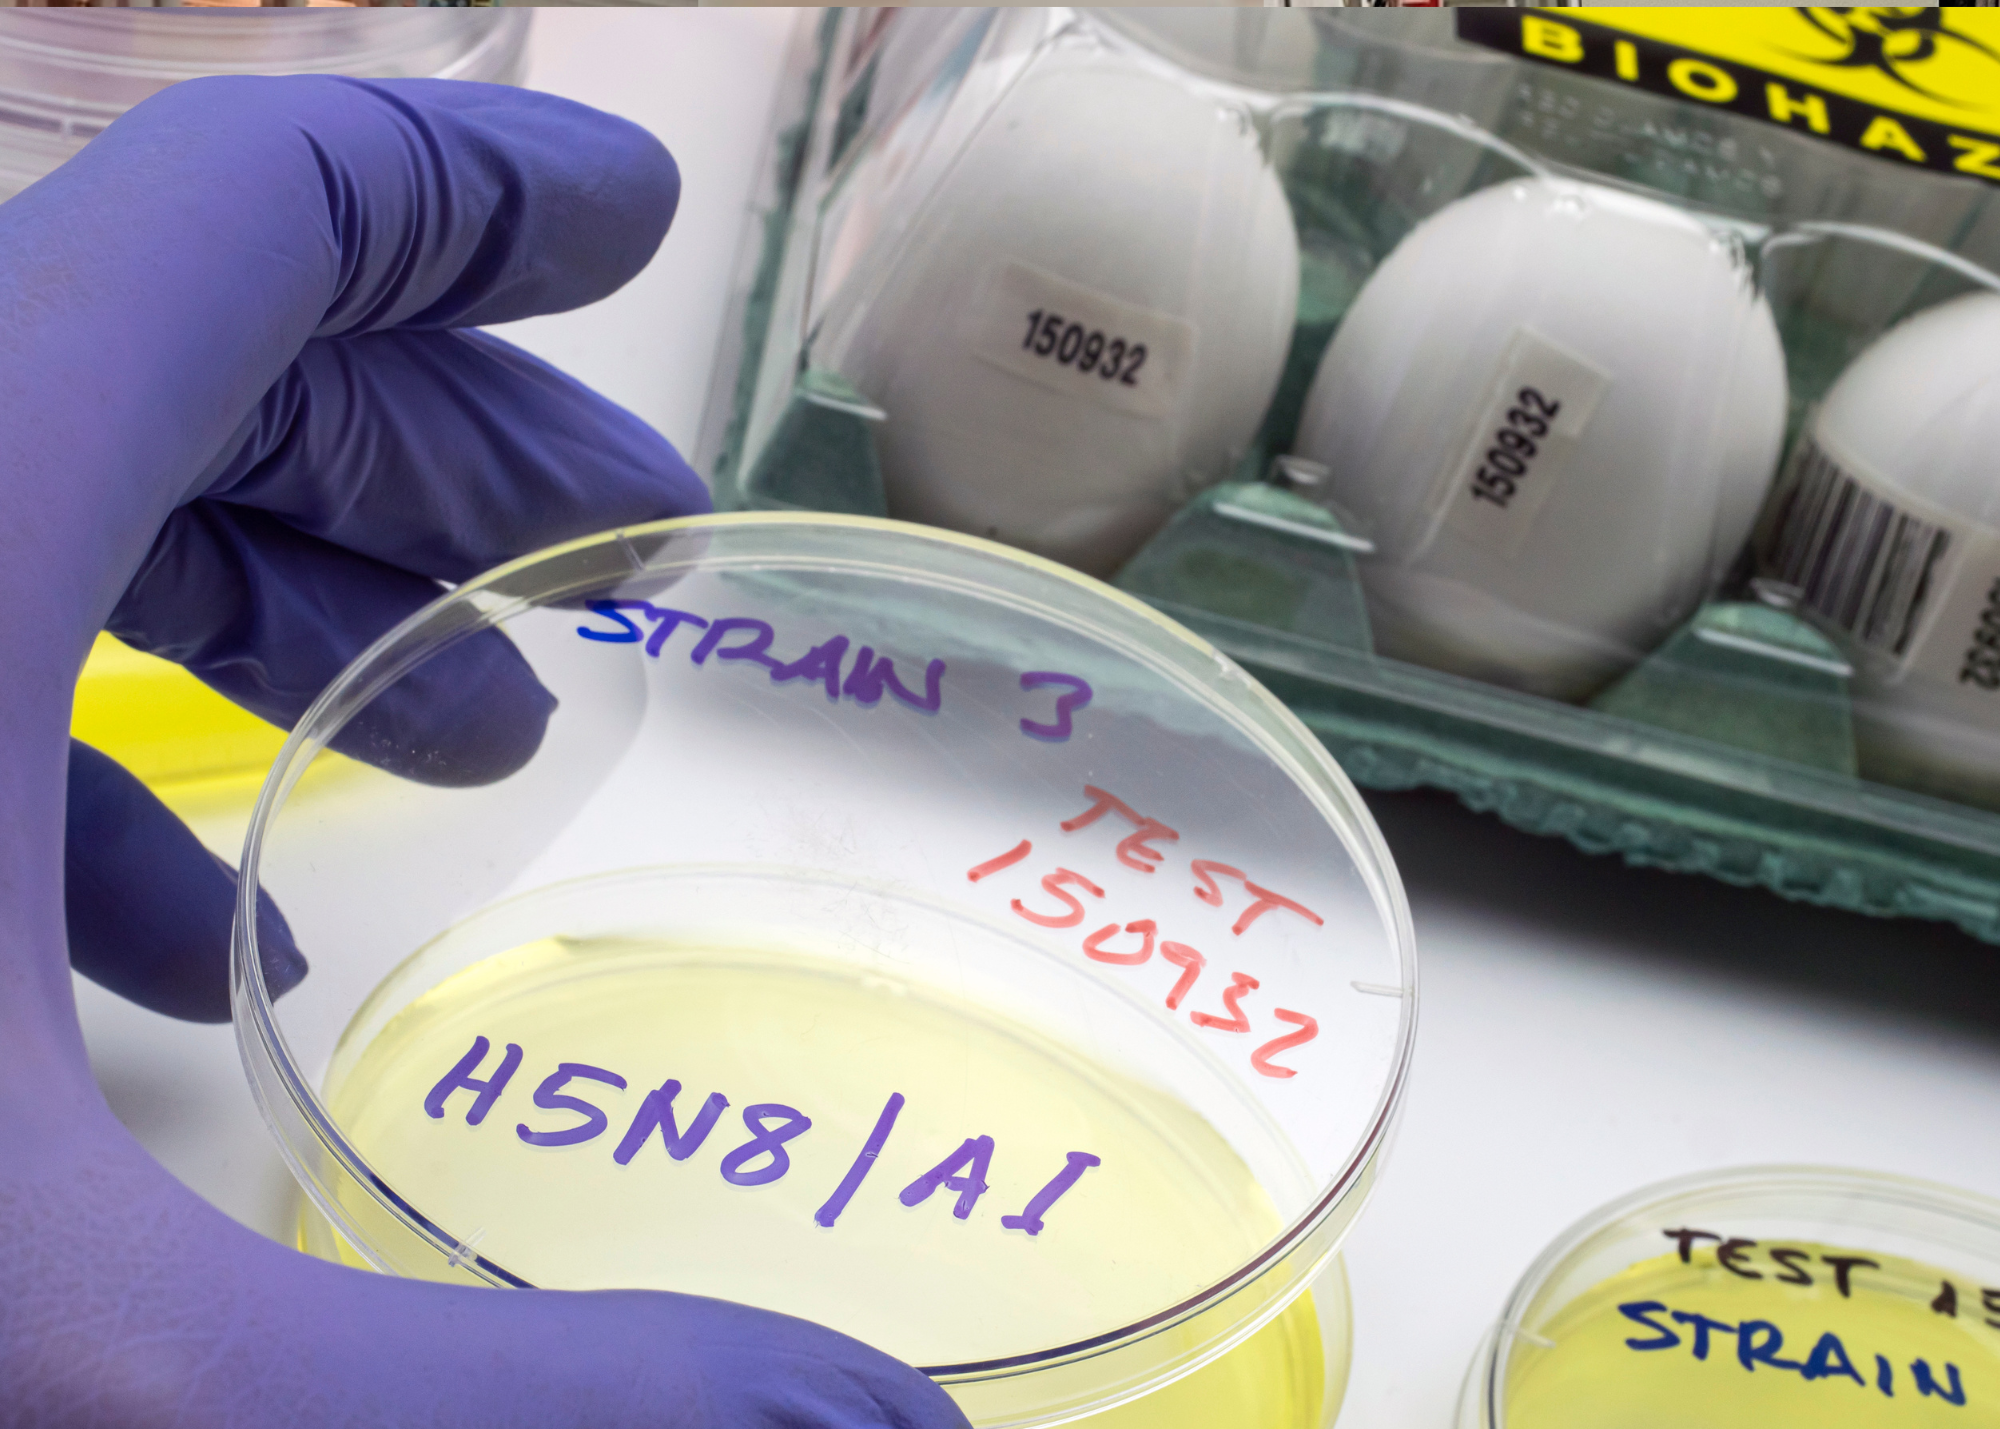

O Ministério da Agricultura e Pecuária declarou estado de emergência zoossanitária em todo o território nacional em função de casos de gripe aviária detectados em aves silvestres. A portaria, assinada pelo ministro Carlos Fávaro, foi publicada em edição extra do Diário Oficial da União na noite dessa segunda-feira (22) e tem validade de 180 dias.
A medida, de acordo com a pasta, tem como objetivo evitar que a doença chegue à produção de aves de subsistência e comercial, além de preservar a fauna e a saúde humana. Ainda segundo o ministério, a declaração de estado de emergência zoossanitária possibilita a mobilização de verbas da União e a articulação com outros ministérios, organizações governamentais nas três instâncias e não governamentais.
Novos casos confirmados
Na tarde dessa segunda-feira (22), o Laboratório Federal de Defesa Agropecuária de São Paulo confirmou três novos casos positivos para influenza aviária (H5N1) no Espírito Santo, que estavam em investigação desde a semana passada.
Em nota, o ministério informou que as aves silvestres da espécie Thalasseus acuflavidus (nome popular trinta-réis-de-bando) foram encontradas nos municípios de Linhares, Itapemirim e Vitória.
Até o momento, são oito casos confirmados em aves no país: sete no Espírito Santo, nos municípios de Marataízes, Cariacica, Vitória, Nova Venécia, Linhares e Itapemirim; e um no estado do Rio de Janeiro, em São João da Barra. Além da espécie Thalasseus acuflavidus, há ainda aves da Sula leucogaster (atobá-pardo) e Thalasseus maximus (trinta-réis real).
A orientação da pasta é que a população não recolha aves que encontrar doentes ou mortas e acione o serviço veterinário mais próximo, no intuito de evitar que a doença se espalhe.
Ainda segundo o governo, não há mudanças no status brasileiro de livre da influenza aviária de alta patogenicidade perante a Organização Mundial de Saúde Animal, por não haver registro na produção comercial.
Feiras com aglomeração de aves
A portaria também prorroga, por tempo indeterminado, a suspensão da realização de exposições, torneios, feiras e outros eventos com aglomeração de aves e a criação de aves ao ar livre, com acesso a piquetes sem telas na parte superior, em estabelecimentos registrados no ministério.
“A medida se aplica a quaisquer espécies de aves de produção, ornamentais, passeriformes, aves silvestres ou exóticas em cativeiro e demais aves criadas para outras finalidades”, detalhou a pasta.
Centro de operações de emergência
Também nesta segunda-feira, a Secretaria de Defesa Agropecuária instalou um Centro de Operações de Emergência para coordenação, planejamento, avaliação e controle das ações nacionais referente à gripe aviária.
“O grupo será responsável pela coordenação das ações de prevenção, vigilância e cuidado com saúde pública, bem como a articulação das informações entre outros ministérios, órgãos, agências estaduais e setor privado”, concluiu o ministério.
Por Paula Laboissière – Repórter da Agência Brasil – Brasília